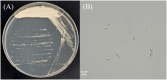

Exploring Fungal Diversity in Marine Plastic (PET) Wastes and Seafoam in Udo Island, South Korea, with Reports of Two New Species (Leptospora conidiifera and Neodevriesia oceanoplastica)
- PMID: 41089594
- PMCID: PMC12517416
- DOI: 10.1080/12298093.2025.2566528
Exploring Fungal Diversity in Marine Plastic (PET) Wastes and Seafoam in Udo Island, South Korea, with Reports of Two New Species (Leptospora conidiifera and Neodevriesia oceanoplastica)
Abstract
Marine fungi play a crucial role in maintaining the ocean ecosystem functions by participating in organic matter degradation, carbon and nitrogen biogeochemical cycles, and interactions with other marine organisms. Nevertheless, many marine habitats remain poorly explored for fungal diversity, as fungi have historically been overlooked in marine research. In this study, we investigated marine fungi in two underexplored coastal habitats (PET plastic waste and seafoam) collected from the intertidal zone of Udo Island, South Korea. A total of 88 fungal strains were isolated and identified as 45 taxa (22 taxa from PET waste and 24 from seafoam) based on multigene phylogenetic analysis and morphological characteristics. The distinct fungal communities recovered from PET plastic waste and seafoam highlight the ecological value of anthropogenic and ephemeral marine habitats. Among these, we report two novel species - Leptospora conidiifera sp. nov. and Neodevriesia oceanoplastica sp. nov. - along with five previously unrecorded marine fungi species in Korea. These findings suggest that the two habitats can serve as reservoirs of unique fungal biodiversity and marine fungi may play unrecognized roles in marine nutrient cycling and microbial interactions.
Keywords: Marine plastic waste; PET; marine fungi; seafoam; unexplored species.
© 2025 The Author(s). Published by Informa UK Limited, trading as Taylor & Francis Group on behalf of the Korean Society of Mycology.
Conflict of interest statement
The authors declare that they have no conflict of interest.
Figures

References
LinkOut - more resources
Full Text Sources